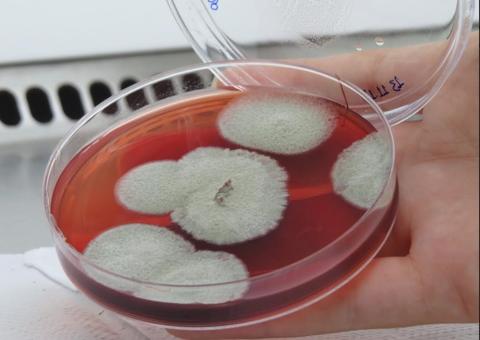
Fungos encontrados no rio Amazonas podem auxiliar no combate ao câncer

Manaus/AM - Escola Municipal Rosa Sverner, na rua das Azaleias, no bairro Jorge Teixeira, zona Leste, foi a unidade de ensino escolhido para receber a segunda edição de 2019 da ação itinerante Prefeitura + Presente na manhã deste sábado, 26/1. O projeto é realizado pela Prefeitura de Manaus, sob coordenação da Ouvidoria e Proteção ao Consumidor (Procon Manaus), e busca levar para perto da população serviços oferecidos pelo município e órgãos e empresas parceiros.
Ao todo, foram 30 serviços ofertados como clínico-geral, aferição de pressão, psicólogos, conselho tutelar, atividades lúdicas, manicure, higiene bucal, limpeza facial, massoterapia, corte de cabelo masculino, cadastro de emprego, entrega de mudas, além de palestras sobre saúde bucal e distribuição de kits de escovação e folderes sobre tuberculose, tabagismo, hipertensão e diabetes.
A dona de casa Lenira Santana, 36, chegou cedo para garantir o atendimento na especialidade clínico-deral e disse estar feliz com a realização do projeto. “Quando reúne vários serviços em um só lugar, como essa ação, é muito bom. Em outros lugares precisa agendar, pegar senha e aqui tudo é bem mais rápido, além do atendimento ser excelente”, avaliou.
Já o pedreiro Expedito Paiva, 31, separou a manhã para realizar consultas no oftalmologista e contou que decidiu ir ao local após saber da agilidade do atendimento. “A maioria das pessoas que vêm aqui não tem condições de pagar para realizar esses exames e a facilidade com que os serviços são realizados é ótima. Agora só encomendar os óculos de grau e melhorar a visão”, comentou.
O projeto prevê ainda a revitalização da escola e das vias do entorno no bairro, com ações de tapa-buracos, meio-fio e sarjetas. A unidade de ensino da rede municipal recebeu pintura, requalificação do teto e aparelhos de educação escolar, como quadros e carteiras.
“Essa é a primeira grande ação de 2019 aqui na zona Leste. Isso mostra a ideia do programa que é justamente ser itinerante para que consigamos atender o maior número de zonas geográficas possível. Um programa criado da gestão do prefeito Arthur Virgílio Neto, que é de muita utilidade para a população, trazendo ao mesmo tempo e no mesmo dia mais de trinta serviços para a comunidade, além de entregar a área revitalizada”, destacou o ouvidor e coordenador do Procon Manaus, Rodrigo Guedes.
A Ouvidoria Municipal e o Procon Manaus trabalham em benefício do cidadão e consumidor manauara com o propósito de aproximar ainda mais a Prefeitura de Manaus da população, através de tais serviços, estando disponível para dúvidas e sugestões pelo 0800-092-0111.

Aviso